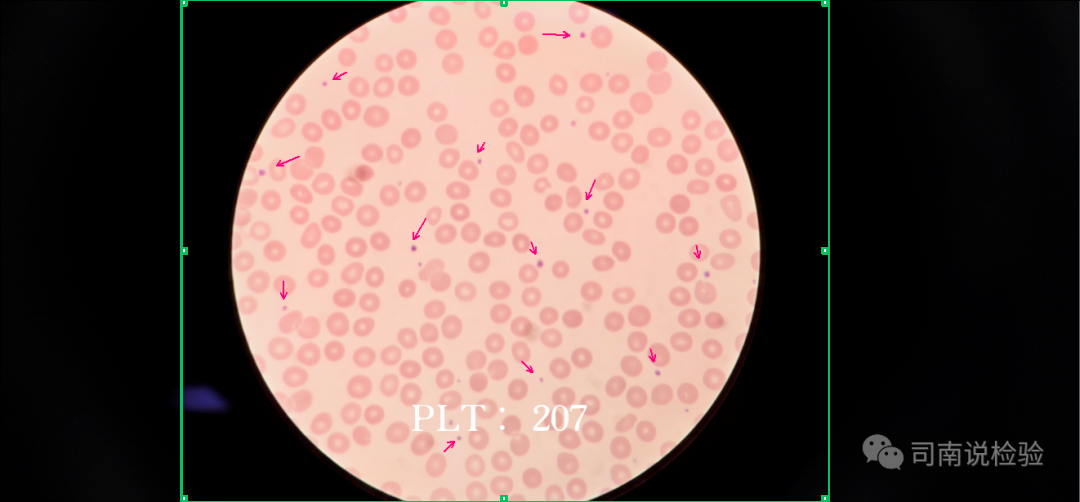

清晨的阳光透过病房的玻璃窗洒落进来,让人感到暖意融融。病房的工作一如既往地有序进行着,突然护士站的呼叫铃急促响了起来,医生赶到病房,患者焦急地问:医生,是不是搞错了,血液不是红色的?为什么我输的血液是黄色的?

医生听后深深地舒了一口气,说道:“这是个有趣的问题,也恰恰点破了现代输血医学的核心——成分输血。”
我们通常看到的血液是红色的,但输注的血液成分却可能是黄色的。这并非搞错,而是医疗科技“破解血液密码”后,为患者提供的更精准、更安全的治疗。
为什么颜色不同?——血液的“家庭成分”揭秘
我们可以把一袋全血看作一个“家庭”,里面住着几位成员,各有不同的外貌和职责:
1.红细胞(红色):家庭里的“氧气搬运工”。它们含有大量的血红蛋白(含铁),因此呈现红色。它们负责将氧气从肺部输送到全身各组织。

2.血浆(淡黄色):家庭里的“营养运输车和后勤保障部队”。约占血液体积的55%,是淡黄色液体,主要成分是水、蛋白质(如白蛋白、免疫球蛋白、凝血因子)、电解质等。它负责运输营养物质、激素,维持胶体渗透压和酸碱平衡,并提供凝血物质。

3.血小板(黄色):家庭里的“紧急维修工”。它们本身是微小的细胞碎片,聚集在血浆中,呈现淡黄色混悬液。当血管损伤时,它们会第一时间聚集到伤口处,形成初步止血栓子。
4.冷沉淀(黄色沉淀物):从血浆中进一步分离出的“特种凝血因子包”。富含纤维蛋白原、凝血因子VIII等,用于治疗特定凝血功能障碍疾病。

为什么要分开输?成分输血的“精准治疗”理念
过去输全血,就像需要砖头时,却把整栋房子都搬过来,不仅效率低,还可能带来不必要的负担和风险。成分输血的优点在于:
1.对症下药,提高疗效:患者缺什么就补什么。贫血补红细胞,凝血功能差补血小板或冷沉淀,烧伤或低蛋白血症补血浆。
2.减少不良反应:全血中的某些成分(如血浆蛋白、白细胞)可能是致敏源,去除它们能显著降低发热、过敏等输血反应。
3.节约血液资源:一袋全血可以分离制备成多种成分,输给不同需要的患者,使宝贵的血液资源得到最大化利用。
4.降低传染风险:在制备过程中,一些血液成分可以进行特殊的病原体灭活处理,进一步保障安全。
技术如何实现?——解锁奥秘的“科技钥匙”
1.大容量离心机:像“智能分选机”一样,根据血液各成分的比重不同,通过离心力将它们清晰地分层。
2.全自动血液分离设备:在密闭无菌系统中,按程序精确地将红细胞、血浆、血小板等分离并收集到不同的血袋中。
3.冷链技术与添加剂:确保每一种成分在最适合的温度和营养环境中储存,维持其活性与功能。

所以,当您看到一袋黄色的液体(血浆或血小板)或一袋深红色的液体(红细胞)输给患者时,这正体现了现代医学的精准与智慧。它不再是简单的“补血”,而是一场目标明确的“成分支援战”。
患者的疑问,恰恰是一个绝佳的科普契机。了解这些知识,能让我们更理解输血过程,减少疑虑,同时也对无偿献血者和医学科技工作者多一份敬意——正是他们的奉献与创新,共同解锁了血液的奥秘,更好地守护我们的健康。
